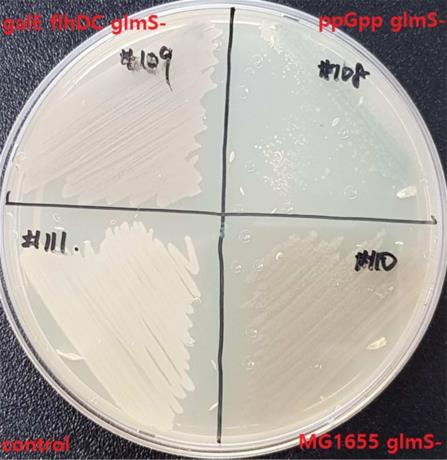

출원번호 : 10-2020-0034639 (출원일: 2020-03-20)
등록번호 : 10-2224855 (등록일: 2021-03-02)
특허권자 : 충남대학교산학협력단
요약 : 본 발명은 종양부위에 표적화되어 항암활성을 갖는 인디루빈을 생합성 및 분비하는 것과 함께 면역 자극을 유도하여 항암 치료에 효과적으로 사용될 수 있는 신규 살모넬라 균주 및 이를 포함하는 항암 조성물에 관한 것으로, 보다 상세하게는 fmo(flavin-containing monooxygenase) 유전자와 tnaA(tryptophanase) 유전자를 포함하는 유전자 구조물로 형질전환되어 암 부위에서 인디루빈을 생산하는 항암 약독화 살모넬라 균주 및 이를 포함하는 항암 조성물에 관한 것이다.
대표청구항 : fmo(flavin-containing monooxygenase) 유전자와 tnaA(tryptophanase) 유전자를 포함하는 플라스미드로 형질전환되어 암 부위에서 인디루빈을 생산하는 항암 약독화 살모넬라 균주.
상세링크 : http://newsd.wips.co.kr/wipslink/api/dkrdshtm.wips?skey=3521112001907